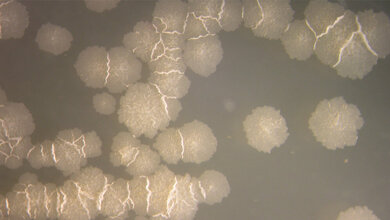
Tuberkulose_Bild_IMM_UZH_24062016.jpg Langsam wachsende Tuberkulose-Bakterien.

Nicht nur Waren und Menschen reisen heute innerhalb weniger Stunden um die Welt. Im Zeitalter der Globalisierung können sich auch Krankheitserreger rasend schnell ausbreiten. Um Epidemien zu verhindern, müssen schnell neue Impfstoffe hergestellt werden.
Ein neues Verfahren, entwickelt von einem interdisziplinären Team der Fraunhofer-Gesellschaft, hilft die Krankheitserreger zur Herstellung von Impfstoffen schnell und vollständig abzutöten, ohne dabei die äußere Form der Viren, Bakterien oder Parasiten zu beeinträchtigen. Der Totimpfstoff, der so entsteht, ist für den Organismus ungefährlich, bewirkt aber, dass das Immunsystem Antikörper bildet, die vor einem Ausbruch der Krankheit schützen.
Bisher werden die Krankheitserreger in Impfstoffen meist mithilfe von Chemikalien inaktiviert. Diese Methode habe jedoch Nachteile, erläutert der IPA-Gruppenleiter Martin Thoma: „Die chemische Behandlung ist zeitaufwendig und lässt sich nicht in einen kontinuierlichen Produktionsprozess integrieren. Außerdem bleiben mitunter Reste der Chemikalien im Impfstoff zurück, die dann in den menschlichen Körper gelangen“.
Inaktivierung von Erregern mithilfe von Elektronenstrahlen
Fünf Jahre hat das IPA-Team zusammen mit Gruppen aus drei weiteren Fraunhofer-Instituten an dem neuen „Verfahren für die Inaktivierung von Erregern mithilfe von niederenergetischen Elektronenstrahlen“ getüftelt. Die Forschung wurde von der Bill & Melinda Gates Foundation mit 1,8 Millionen Dollar gefördert.
„Entscheidend für den Erfolg war die interdisziplinäre Zusammenarbeit“, betont Thoma. Die Experten vom Fraunhofer-Institut für Organische Elektronik, Elektronenstrahl- und Plasmatechnik FEP entwickelten die Anlage, die niederenergetische Elektronen exakt so dosiert, dass sie das Erbgut der Erreger in sehr kleinen Flüssigkeitsmengen zerstört. Die Forscherinnen und Forscher am Fraunhofer-Institut für Zelltherapie und Immunologie IZI kultivierten verschiedene Erreger – darunter die für Vogel- und Pferdegrippe, prüften, ob diese durch die Bestrahlung vollständig inaktiviert wurden und ob sie einen effektiven Impfschutz bieten.
Das Team am Fraunhofer-Institut für Grenzflächen- und Bioverfahrenstechnik IGB untersuchte die dosisabhängige Inaktivierung. Und Thomas Team erarbeitete am IPA die Module, die dafür sorgen, dass die Flüssigkeit mit den Erregern genau in der richtigen Schichthöhe und Geschwindigkeit den Elektronenstrahl passiert. „Die Automatisierung dieses Prozesses war eine besondere Herausforderung, weil eine hinreichend homogene Dosisverteilung bei einer Bestrahlung mit niederenergetischen Elektronen (circa 200 keV) nur bis zu einer Eindringtiefe von circa 200 Mikrometer in Flüssigkeiten gewährleistet ist. Man muss die Proben daher mit einer sehr kontrollierten Schichthöhe und Geschwindigkeit durch die Strahlung führen“, berichtet der Gruppenleiter.
Erste Forschungs- und Versuchsanlage in Leipzig
Speziell für geringe Probengrößen wurde ein Modul entwickelt, das die Erregersuspension in Beuteln unter der Elektronenquelle durchführt. Ein anderes Modul, die „Liquid Roll“, eignet sich für die Inaktivierung von Erregern in großen Flüssigkeitsmengen: Hier wird eine Rolle mit der Erregersuspension benetzt und nach der Bestrahlung wieder abgestreift. Die Methode lässt sich in die industrielle Produktion von Impfstoffen integrieren.
Eine erste Forschungs- und Versuchsanlage ging unlängst am Fraunhofer IZI in Leipzig in Betrieb. Mit ihr können die Teams jetzt die Technik weiter optimieren und zusammen mit ihren Industriepartnern die Produktion von verschiedenen Impfstoffen testen.
Quelle: Fraunhofer IPA, 09.10.2018
Artikel teilen